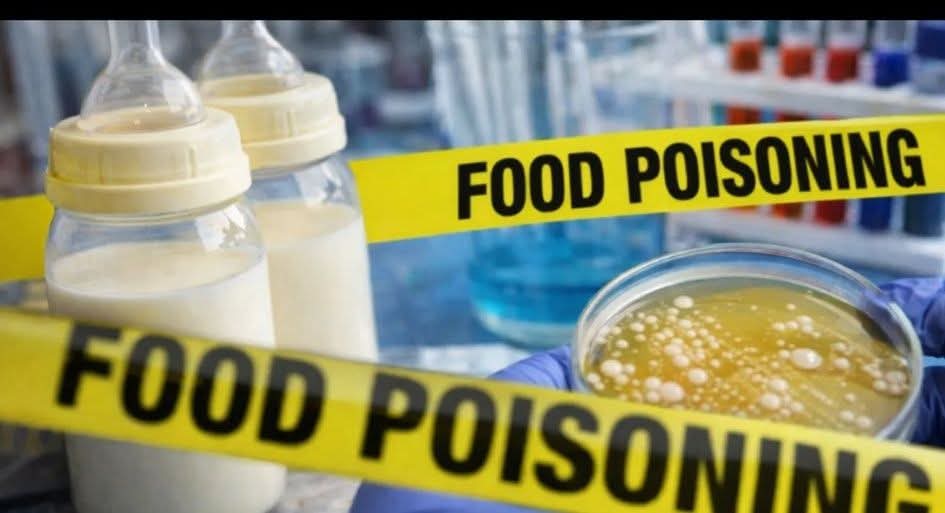

كتبت ـ مها سمير
أعلنت السلطات الصحية في الولايات المتحدة، يوم الجمعة، عن تسجيل حالات تسمم غذائي طالت عشرات الأطفال، يُشتبه في ارتباطها باستخدام حليب مجفف كامل الدسم ملوّث يدخل في تصنيع حليب الأطفال الذي تنتجه شركة «باي هارت».
ووفقًا لمسؤولين في القطاع الصحي، أظهرت الفحوصات التي أجرتها إدارة الغذاء والدواء الأميركية (FDA) وجود نوع من البكتيريا القادرة على التسبب في المرض في عينتين على الأقل مرتبطتين بمنتجات حليب الأطفال.
وأوضحت الإدارة أن البكتيريا التي عُثر عليها داخل عبوة حليب غير مفتوحة تطابقت مع عيّنة مأخوذة من طفل مصاب، كما تطابقت مع التلوث المكتشف في عينات من مسحوق الحليب العضوي كامل الدسم المستخدم في تصنيع منتجات الشركة.
وأضافت إدارة الغذاء والدواء أن الاختبارات كشفت أيضًا عن تلوث في عيّنة من الحليب المجفف كامل الدسم المورّد إلى شركة «باي هارت»، حيث تبيّن أن الجرثومة المكتشفة فيها مطابقة لتلك الموجودة في عيّنة من المنتج النهائي لحليب الأطفال.
وفي بيان رسمي، أكدت الإدارة أن النتائج الحالية لا تزال غير حاسمة، مشيرة إلى أن التحقيقات مستمرة لتحديد المصدر الدقيق للتلوث واتخاذ الإجراءات اللازمة لضمان سلامة المنتجات الغذائية، خاصة تلك المخصصة للأطفال.